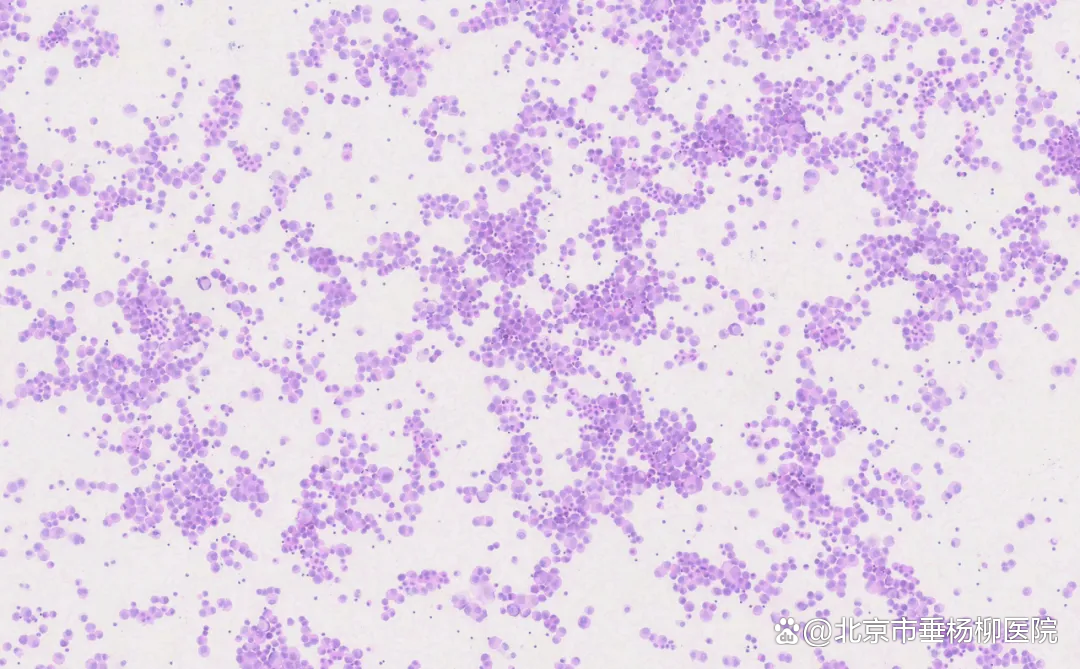

患者男性,76岁,因受凉后出现咳嗽、咳痰,伴咽痛、咳白痰就诊于清华大学附属垂杨柳医院呼吸与危重症医学科门诊,后入院治疗。在对症治疗后患者自觉憋气,夜间不能平卧,无明显少尿、下肢水肿。胸部CT示:右侧胸腔积液伴右肺下叶膨胀不全。临床抽取适量胸水送至病理科做细胞涂片检查。

胸水传统细胞学涂片:镜下细胞量丰富,弥漫分布,细胞核大异型,部分胞浆丰富,染色质较细腻,核分裂象易见。
细胞学判读结果:符合恶性肿瘤细胞。


细胞沉渣石蜡包埋HE切片:血性背景中可见大量恶性肿瘤细胞,粘附性差,核形不规则,可见泡状核,部分胞浆丰富,核分裂象易见。


细胞沉渣免疫组化显示肿瘤细胞:TTF-1(-),Napsin-A(-),EMA(+),Calretinin(间皮+),Desmin(间皮+),CK7(间皮+),CK5(间皮+),CK(间皮+),Vimentin(+),LCA(淋巴细胞+),CgA(个别+),INI1(+),BRG1(部分-,部分弱+),BRM(-),WT-1(间皮+),Syn(+),CD56(-)。
(胸水)细胞沉渣石蜡包埋HE切片病理诊断:可见恶性肿瘤细胞,分化较差,免疫组化结果提示BRG1蛋白表达显著降低、BRM蛋白表达缺失,伴有神经内分泌表达,符合SMARCA4缺失型未分化肿瘤。
细胞学病理诊断结果出来后,对患者完善影像学检查示:1.右肺上叶、下叶多发高代谢结节、肿物,考虑肺癌伴肺内转移,右肺下叶外基底段较大肿物考虑为原发瘤可能;2.右侧胸膜转移瘤;3.大脑双侧枕叶转移瘤;4.右侧臀小肌高代谢结节,首先考虑转移瘤;5.纵隔、右前心膈角、右肺门部及肝尾叶后旁多发淋巴结转移。胸外科对患者进行胸腔镜下右肺下叶楔形切除术+胸膜活检术+腔内肿瘤热灌注治疗术,术中发现胸腔内广泛转移,肺表面多处渗血、出血灶以及胸腔内大量血性胸水。


术后组织病理诊断结果:恶性肿瘤,分化差,结合免疫组化结果,符合SMARCA4缺失型未分化肿瘤。
SMARCA4基因位于19号染色体,编码具有7个结构域的BRG1蛋白,是组成SWI/SNF染色体重塑复合物的核心亚基,1984年首次在酵母中发现。SMARCA4缺失的未分化肿瘤在2021年被世界卫生组织(WHO)列为一类特殊表型的上皮来源的NSCLC,其是一种高级别的恶性肿瘤,总体预后差,中位生存期4-7个月,化疗效果差。《中华医学会肺癌临床诊疗指南(2023版)》在“其他上皮源性肿瘤部分”中对SMARCA4缺陷型未分化肿瘤进行了阐述,并建议对于分化差的癌或肿瘤,可进行SMARCA4(BRG-1)免疫组化检测。
细胞学胸水涂片检查是一种通过分析胸水中细胞成分来查找肿瘤细胞、鉴别胸水良恶性的关键检查,对肿瘤的诊断、分期及治疗方案的选择具有重要意义。
参考文献:
1.Yuan J,Chen K, Zhang W,et al.Structure of human chromatin-remodelling PBAF complex boud to a nucleosome.Nature,2020,605(7908):166-171.
2.Nicholson AG,Tsao MS,Beasley MB,et al.The 2021 WHO classification of lung tumors:impact of advances since 2015.J Thorac Oncol,2022,17(3):362-387.
本文仅限于公益科普及学术交流,如有不适请及时就医,文中部分资料来源文献,侵删。





